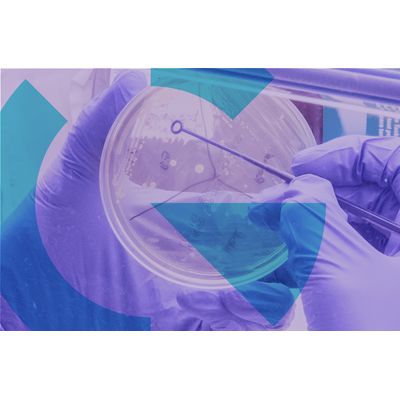

BiomX - Phage Cocktails (Or Combinations)
BiomX develops phage cocktails (or combinations) that target and kill specific pathogenic bacteria. Our phage cocktails, which are optimized through algorithms and experimental validation (in-vitro and in-vivo), contain multiple natural and/or engineered phage. The phage are selected to have complementary functions such as wide target bacterial host range and the ability to avoid the development of bacterial resistance, among other characteristics.
Bacteriophage, or phage, are viruses that target bacteria and are considered inert to mammalian cells. Phage are natural predators of bacteria and are found wherever bacteria exist. Phage are specific to particular bacterial species or strains, targeting and killing them without disrupting other neighboring, potentially beneficial, bacteria.

Phages target and rapidly kill their bacterial hosts by amplifying inside these bacteria and consequently releasing new phage by bursting through the host cell membrane into the surrounding environment. These newly released phage infect and kill additional nearby bacterial cells in a reiterative process that leads to elimination of the target bacteria
The BOLT platform (“BacteriOphage Lead to Treatment”) is comprised of proprietary computational tools, automated screening, synthetic engineering capabilities and various validation assays aimed at developing natural or engineered phage cocktails that target a particular pathogenic bacteria. We apply the platform to develop phage cocktails directed through two development paths as outlined below.

Tailored to target strains of a specific patient within 6-8 weeks. Running such production suites in parallel for multiple patients allows to conduct a clinical Personalized proof of concept within 12-18 months from project initiation.

Optimized for bacterial host range, resistance, other factors, to target a broad patient population as a go to market product. Usually requires 1-2 years to develop.

The bacteria present in our gut have shown promise as a predictive tool for the existence and staging of medical conditions such as IBD, liver disease, colorectal cancer and cardiovascular diseases. Recent publications have also demonstrated the potential to predict response to specific therapeutics for IBD and immuno-oncology based on bacterial gut composition. Our first-of-its-kind XMarker platform uses a unique metagenomics-based approach to discover predictive microbial genomic signatures that can be further developed into biomarkers. The platform combines ultra-high-resolution DNA analysis, AI techniques and high-scale cloud computing resources to build classifiers of high sensitivity and specificity.
